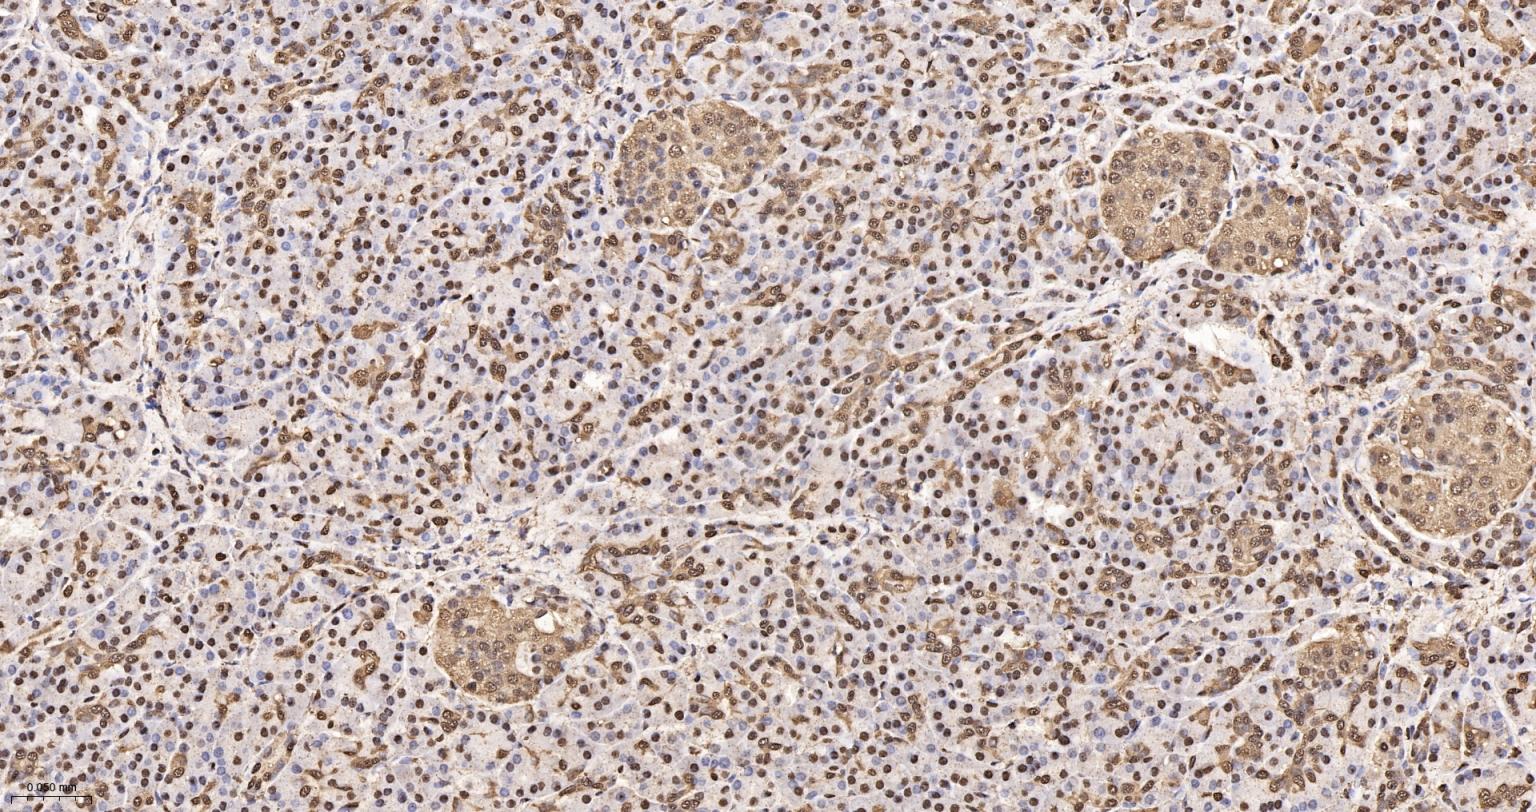
3-磷酸甘油醛脱氢酶(内参)重组兔单抗
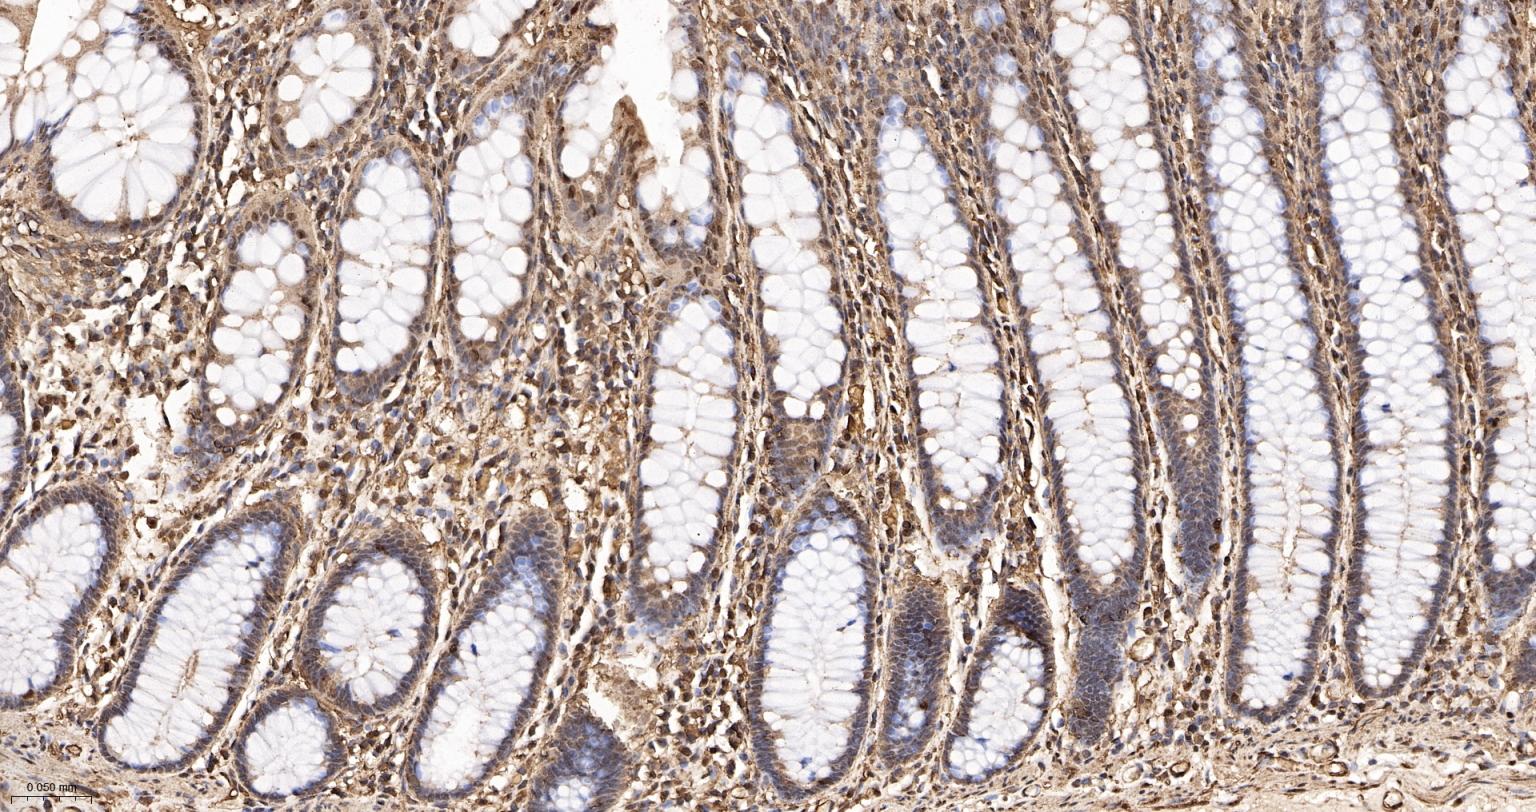
3-磷酸甘油醛脱氢酶(内参)重组兔单抗
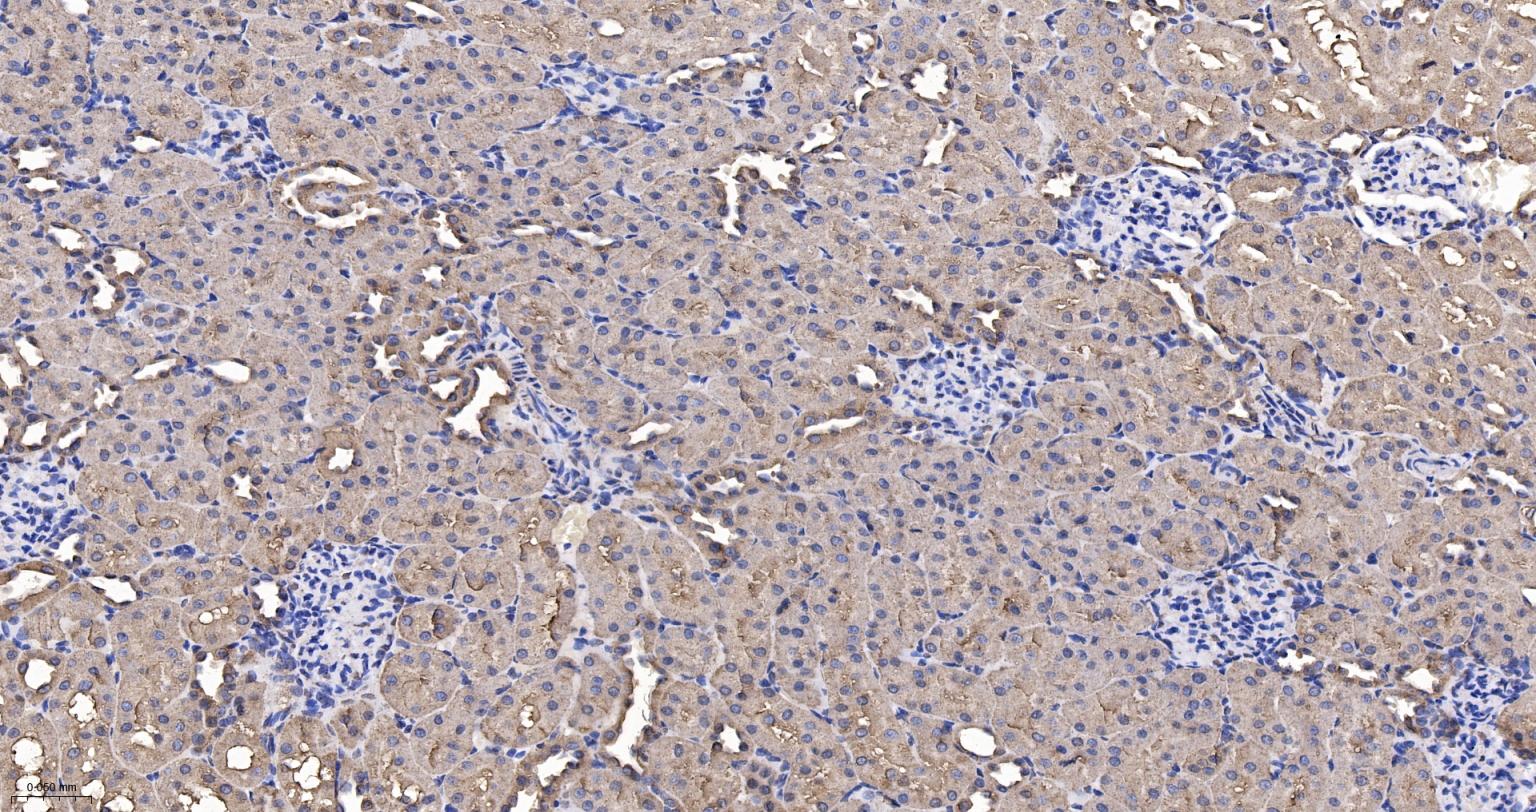
3-磷酸甘油醛脱氢酶(内参)重组兔单抗

Cancer > Cancer Metabolism > Metabolic signaling pathway > Metabolism of carbohydrates
Isotype/Loading Controls > Loading Controls > GAPDH
Metabolism > Pathways and Processes > Metabolic signaling pathways > Carbohydrate metabolism
Metabolism > Pathways and Processes > Metabolic signaling pathways > Energy transfer pathways > Energy Metabolism
Metabolism > Types of disease > Cancer
Metabolism > Types of disease > Neurodegenerative disease
Neuroscience > Neurology process > Neurodegenerative disease > Alzheimer's disease
Neuroscience > Neurology process > Neurodegenerative disease > Huntington's disease
Loading Control
Glyceraldehyde 3 phosphate dehydrogenase (GAPDH) is well known as one of the key enzymes involved in glycolysis. As well as functioning as a glycolytic enzyme in cytoplasm, recent evidence suggests that mammalian GAPDH is also involved in a great number of intracellular proceses such as membrane fusion, microtubule bundling, phosphotransferase activity, nuclear RNA export, DNA replication, and DNA repair. During the last decade a lot of data appeared concerning the role of GAPDH in different pathologies including prostate cancer progression, programmed neuronal cell death, age related neuronal diseases, such as Alzheimer's and Huntington's disease. GAPDH is expressed in all cells. It is constitutively expressed in almost all tissues at high levels. There are however some physiological factors such as hypoxia and diabetes that increase GAPDH expression in certain cell types. GAPDH molecule is composed of four 36kDa subunits.

| 应用 | 已检合格种属 | 预测种属 | 推荐稀释比例 |
|---|---|---|---|
| WB | Human, Mouse, Rat | Zebrafish, Monkey | 1:5000-500000 |
| IHC-P | Human, Mouse, Rat | Zebrafish, Monkey | 1:200-1000 |
| IHC-F | Human, Mouse, Rat | Zebrafish, Monkey | 1:200-1000 |
| IF | Human, Mouse, Rat | Zebrafish, Monkey | 1:200-1000 |
| Flow-Cyt | Human, Mouse | Rat, Zebrafish, Monkey | 1ug/Test |
| ICC/IF | Human, Mouse | Rat, Zebrafish, Monkey | 1:100-500 |
交叉反应: Human, Mouse, Rat (predicted: Zebrafish, Monkey)
暂无相关产品
Homotetramer (PubMed:16239728, PubMed:16510976).
Interacts with TPPP; the interaction is direct (By similarity).
Interacts (when S-nitrosylated) with SIAH1; leading to nuclear translocation (By similarity).
Interacts with RILPL1/GOSPEL, leading to prevent the interaction between GAPDH and SIAH1 and prevent nuclear translocation (By similarity).
Interacts with CHP1; the interaction increases the binding of CHP1 with microtubules (By similarity).
Associates with microtubules (By similarity).
Interacts with EIF1AD, USP25, PRKCI and WARS1 (PubMed:11724794, PubMed:16501887, PubMed:15628863, PubMed:20644585).
Interacts with phosphorylated RPL13A; inhibited by oxidatively-modified low-densitity lipoprotein (LDL(ox)) (PubMed:22771119).
Component of the GAIT complex (PubMed:15479637).
Interacts with FKBP6; leading to inhibit GAPDH catalytic activity (PubMed:19001379).
Interacts with TRAF2, promoting TRAF2 ubiquitination (PubMed:23332158).
Interacts with TRAF3, promoting TRAF3 ubiquitination (PubMed:27387501).
Cytoplasm, cytosol. Nucleus. Cytoplasm, perinuclear region. Membrane. Note=Translocates to the nucleus following S-nitrosylation and interaction with SIAH1, which contains a nuclear localization signal. Postnuclear and Perinuclear regions.
#Acetylation
Belongs to the glyceraldehyde-3-phosphate dehydrogenase family.
Has both glyceraldehyde-3-phosphate dehydrogenase and nitrosylase activities, thereby playing a role in glycolysis and nuclear functions, respectively (PubMed:3170585, PubMed:11724794).
Glyceraldehyde-3-phosphate dehydrogenase is a key enzyme in glycolysis that catalyzes the first step of the pathway by converting D-glyceraldehyde 3-phosphate (G3P) into 3-phospho-D-glyceroyl phosphate (PubMed:3170585, PubMed:11724794).
Modulates the organization and assembly of the cytoskeleton (By similarity).
Facilitates the CHP1-dependent microtubule and membrane associations through its ability to stimulate the binding of CHP1 to microtubules (By similarity).
Component of the GAIT (gamma interferon-activated inhibitor of translation) complex which mediates interferon-gamma-induced transcript-selective translation inhibition in inflammation processes (PubMed:23071094).
Upon interferon-gamma treatment assembles into the GAIT complex which binds to stem loop-containing GAIT elements in the 3'-UTR of diverse inflammatory mRNAs (such as ceruplasmin) and suppresses their translation (PubMed:23071094).
Also plays a role in innate immunity by promoting TNF-induced NF-kappa-B activation and type I interferon production, via interaction with TRAF2 and TRAF3, respectively (PubMed:23332158, PubMed:27387501).
Participates in nuclear events including transcription, RNA transport, DNA replication and apoptosis (By similarity).
Nuclear functions are probably due to the nitrosylase activity that mediates cysteine S-nitrosylation of nuclear target proteins such as SIRT1, HDAC2 and PRKDC (By similarity).
暂无标记数据
暂无同靶标产品
暂无相关文献
暂无常见问题